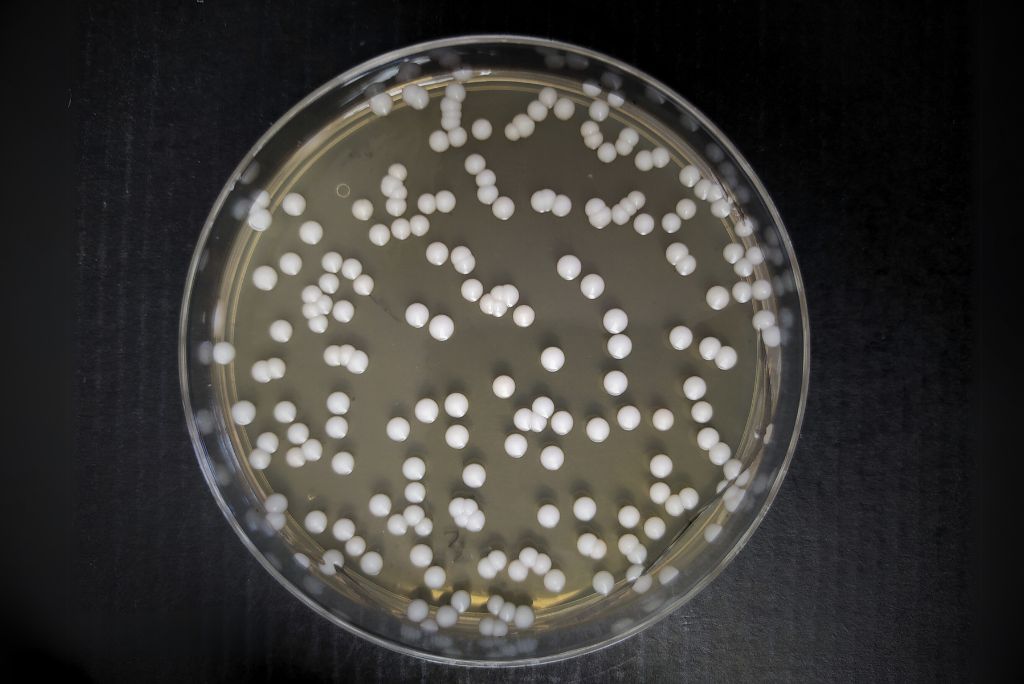
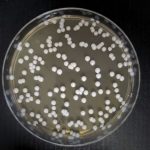

Mikrobiologija ima v vinarstvu zelo pomembno vlogo. Na Kmetijskem inštitutu Slovenije se že vrsto let ukvarjamo z mikrobiološkimi raziskavami grozdja in vina ter imamo na tem področju kar nekaj relevantnih publikacij.
Med predelavo grozdja do vina imamo opravka z rastjo štirih najpomembnejših skupin mikroorganizmov: ne-Saccharomyces kvasovk, ki večinoma prihajajo iz grozdja, Saccharomyces kvasovk iz starterskih kultur ali naravne mikoflore, mlečnokislinskih bakterij (Oenococcus oeni) ter kvasovk in bakterij, ki povzročajo bolezni vina.
V mikrobiološkem laboratoriju opravljamo mikrobiološke analize grozdja, drozge/mošta in vina. Analize opravljamo za potrebe:
- domačih in tujih raziskovalnih projektov,
- diplomskih, magistrskih in doktorskih nalog,
- zunanje naročnike: katere koli fizične ali pravne osebe.
Področje dela
- določanje celokupne koncentracije kvasovk v vzorcu mošta/drozge/vina glede na fiziološko stanje (žive, mrtve, dormantne),
- vrste in zastopanost viabilnih (živih) kvasovk iz rodu Saccharomyces in ne-Saccharomyces ter njihov vpliv na senzorično kakovost vina,
- vsebnost kvasovk rodu Dekkera/Brettanomyces (kvarljivcev) v vinih in detekcija njihovih presnovkov (hlapnih tiolov),
- vpliv uporabe žvepla, temperature vinifikacijskih postopkov, dodatek selekcioniranih kultur kvasovk in bakterij, hrane, količine raztopljenega kisika ter kvasovkam dostopnega dušika v fermentacijskem mediju na mikrobiološko populacijo in kakovost pridelanega vina.
Raziskovalna oprema
- pretočni citometer Cube 6
- bioreaktorji Minifors 2 (3x)
- pretočni hladilnik (water chiller) H150-2100LT
- zaščitna komora – laminarij MV – LFV 12
- inkubator – termostatska omara Memmert
- encimski analizator WineLab touch
- avtoklav Astell AMB 240 (Ecofill)
- centrifuga 12 X 1,5/2,0 mL IKA G-L
- svetlobni mikroskop Nikon Eclipse 80i
- orbitalni stresalnik s funkcijo stresanja/inkubacije MATRIX ORBITAL DELTA PLUS
- oprema za membransko filtracijo Microfil
- elektronski števec bakterijskih kolonij EŠKO 7L